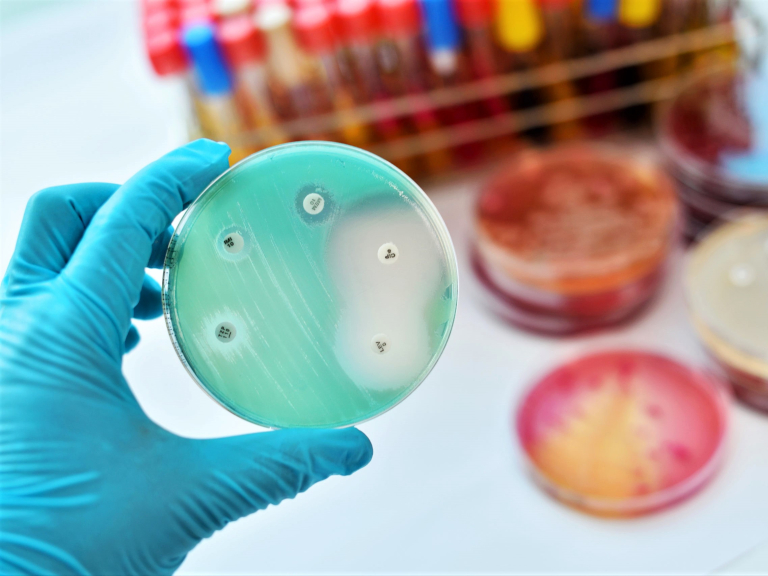

Enfoque estratégico contra resistencia antimicrobiana
Alcanzar acuerdos que permitan abordar el problema con urgencia y evitar el aumento de la mortalidad es prioritario para la OMS.
Si no se toman medidas urgentes, las enfermedades resistentes a los antimicrobianos podrían causar el aumento de la pobreza extrema y 10 millones de muertes anuales en 2050, advirtió la Organización Mundial de la Salud (OMS).
“De continuar la actual tendencia, las intervenciones que requieren estos medicamentos, como trasplantes de órganos, reemplazos de articulaciones y quimioterapia, así como la atención de recién nacidos prematuros, se volverán demasiado peligrosas”, aseguró el presidente de la Asamblea General de la ONU, Volkan Bozkir, durante el Diálogo de alto nivel sobre resistencia a los antimicrobianos.
La falta de regulación, el uso de antibióticos como promotores del crecimiento en animales y la venta libre y por internet han provocado el auge de fármacos falsificados, sin certificación o de mala calidad coincidieron los asistentes al evento semipresencial, junto con considerar imperativo que los productores de alimentos, criadores y agricultores se sumen a estas instancias, ya que son el sector que más utiliza el esquema.
En su intervención, el director general de la OMS, Tedros Adhanom Gebreyesus, hizo un llamado a alcanzar acuerdos e implementar estrategias para abordar la resistencia a los antimicrobianos. “Es vital que juntos otorguemos al manejo de este problema el mismo sentido de urgencia, innovación y solidaridad que hemos visto durante la pandemia por COVID-19”.
“La crisis sanitaria ha ilustrado de forma muy cruda la necesidad de trabajar con todos los sectores con un enfoque integrador que proteja la salud de humanos, animales y el planeta”, aseguró antes de invitar a firmar el documento Acción contra la resistencia antimicrobiana 2021.
Temas Relacionados